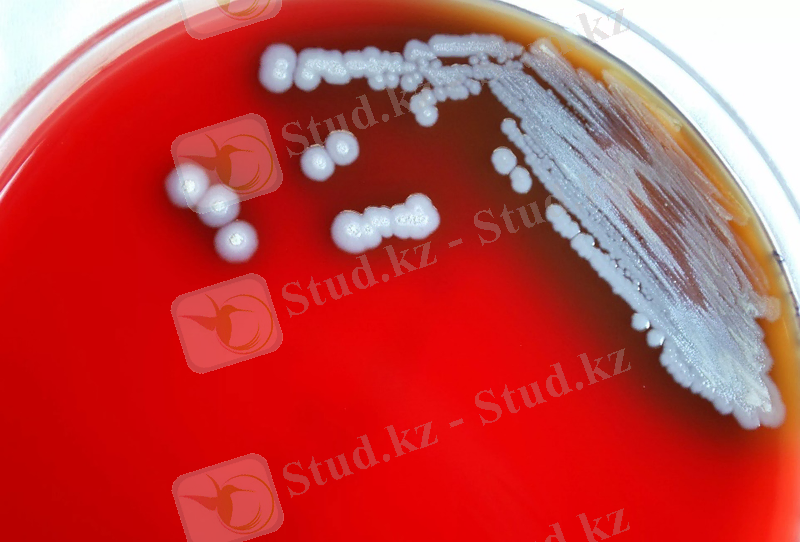
https://im0-tub-kz.yandex.net/i?id=004c7b803b82b63d0159859c12db4aca-l&n=13
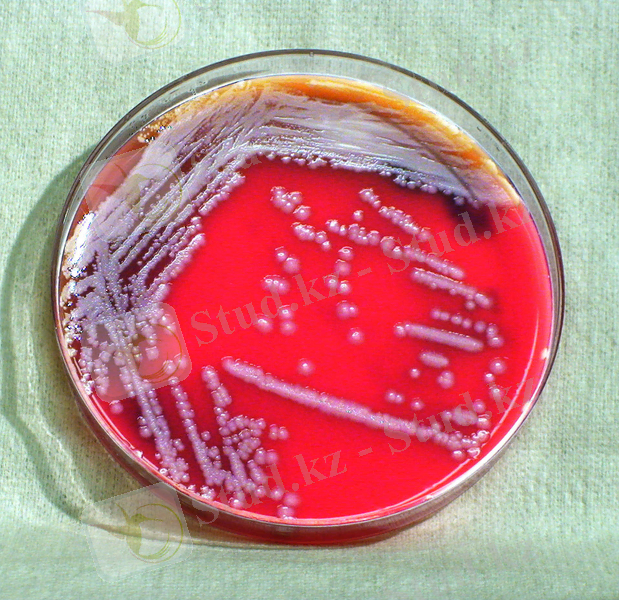
http://res.publicdomainfiles.com/pdf_view/62/13544895619658.jpg

Қазақстан жағдайындағы жылқы маңқасы: клиника, патологиялық-анатомиялық өзгерістер және алдын алу шаралары


Кіріспе
Мал шаруашылығы халқымыздың ата кәсібі, республика саласының басты бір саласы. Сан ғасырлар жинақталған тәжірибесінің нәтижесінде өлкемізде табиғатымен терең үйлескен мал өсірудің ерекше жүйесі қалыптасқан. Сонымен бірге әртүрлі мал ауруларының алдын-алып, емдеу де де халқымыздың қол жеткізген жетістіктері де көп.
Жылқының орны қазақ халқы үшін өте бөлек. Сонымен қатар табиғаттың құбылмалы жағдайларына да биімді. Жылқыны бағып күту аса көп шығын шықпайды. Бір жылқы 10-12 қойдың етін береді, таза май мен ет шығымы семіз жылқыда 57-60 % -ға дейін барады . бие сүтінде қант көпкездеседі. Сондықтан одан қымыз ашытады. Қымызда 3-4% -ға жуық таза спирт болады. Оның құрамындағы майыф да, белогы да жұғымды келеді. Бие сүтінде «С» витамині болады. Ол адамды құрқұлақ дертінен сақтайды. Оның үстіне жылқының адам тірлігі үшін пайдасы да алуан түрлі: жесең ет, мінсең, жексең көлік, алуан түрлі жарыстармен ойын-сауық жылқысыз өтпейді.
Жылқы шаруашылығы - мал шаруашылығының жылқы өсіретін саласы. Жылқы шаруашылығы бағалы азық-түліктік ет пен сүт өңдірумен қатар өнеркәсіпке - тері, қыл, ауыл шаруашылығы жұмыстарына - күш-көлік береді, жылқы қанынан емдік вакцина, сарысу, гамма-глобулин жөне қой мен сиырдың төлділігін арттыратын буаз бие қанының сарысуын дайындайды. Кең байтақ жайылымы бар Қазақстанның көптеген аудандарында жылқы шаруашылығымен айналысу тиімді.
Қазақстанда жылқы шаруашылығы асыл тұқымды жылқы өсіру, ет, сүт өндіру, спортта пайдалану бағыттарында дамуда. Сонымен қатар жылқыны кез келген шаруашылықтың күнделікті қажетін өтеу үшін салт мінуге, жүк тасуға т. б. жұмыстарды аткаруға пайдаланады. Асыл тұқымды жылқы өсірумен арнайы мемлекеттік жылқы зауыттарымен қатар, соңғы уақытта жеке азаматтар мен шаруашылықтар да айналысады. Қазақстан жағдайында табиғи жайылым отын мейлінше толық пайдалануға негізделген ет, сүт өндіру бағытындағы жылқы шаруашылығын дамыту мүмкіншілігі зор. Осы ретте жекелеген аймақтардың табиғи жақсы бейімделген етті-сүтті бағытағы көшім, мүғалжар атты жаңа жылқы тұқымдары мен қазақы жылқының таза етті бағыттағы жабы атты жаңа түрі шығарылды. Соңғы кезде жылқы саны Қазақстанда қайтадан көбеюде.
1. Әдебиетке шолу
- Жылқылардың маңқа ауруы
Маңқа - жіті өтетін бір тұяқты малдың контагиозды ауруы, дененің ыстығы көтеріліп, танау мен жұтқыншақтың кілегейлі қабығы іріңді-катаральді қабынып және жақ асты сөл түйіндерінің абцесске айналуымен ерекшеленеді.
Ауру қоздырғышы - Pseudomonas mallei, микроорганизм шар немесе сопақша пішінді, грам оң, қозғалмайды, спора түзбейді, аэробты, жаңа бөлінген штаммдар капсула түзеді.

Сурет 1. Pseudomonas mallei - маңқа қоздырғышы
Патматериалдан жағынды алғанда олар ұзын тізбектелген моншақ тәрізді, бірнеше ондық кокктардан құралған. Қоректік орталарда стрептококкмоншағы жиі қысқа болады. Қоректік орталарда 10 . . . 20 пайыз қан сарысуын, 5 . . . 10 пайыз қан және глюкоза қосқанда өседі. Бір тәулік өткен соң агарда қоздырғыш ұсақ, көрінетін шық тамшыс ына ұқсайтын, колониялар, В-гемолиз алаңы. Токсин бөліп шығарады яғни - гемолизин, лейкоцидин, агрессин, гиалуронидазаны, дезоксирибонуклеазаны. Маңқамен ауырған жылқы оргагнизмінен қоздырғышты таза түрінде тек абцесс кезінде алады. Мұрынды ағындыда маңқа стретококктарын ассоциация кезінде басқа бакткриялармен сонымен қатар іріңді стрептокоокпен табады. Пенициллин мен тетрациклинге сезімтал келеді.

Сурет 2. Маңқа қоздырғышының қоректік ортада өсуі
Физика және химиялық факторларға төзімділігі жоғары. Қида қоздырғыш 1 айға дейін сақталады, глинобитті еденде 9 айға дейін, құрғаьылған іріңде 1 жыл шамасында, пішен, сабан және жылқы шаштарында 20 күнге дейін сақталады. 70 . . . 750С қыздырғанда бір сағат, 850С - 30 минутта шыдайды.
Дезинфекциялық ортада (күйдіргіш қышқылда, формалин, фенол, креолин) кадімгі концентрацияда қоздырғышты 15 . . . 30 минут ішінде өлтіреді.
Географиялық таралуы. Ауру баяғыдан таныс. 1664 жылдан бастап, кейін Виборг және Эрдели (1802) екеуі ауру жануарлардан мұрын ағынынан жұғатынын дәлелдеген. 1888 жылы А. Шютц және т. б. қоздырғышты тапты яғни маңқа стрептокогін. Бүкіл дүние жүзінде кездеседі, сонымен қатар Россияда және Қазақстан Республикасында.
1. 2 Маңқа ауруының індеттік ерекшеліктері
Маңқаға тек бір тұяқты жануарлар ғана сезімтал: жылқылар, қашыр, есек, мулалар 2 айға дейін. Бұл ауру туғаннан кейін 10 күн өткенде пайда болады. Жас оргаизм резистенттілігі төмендегенде 1 айдан 20 жылға дейін өзгере алады. Маңқа ауруы жылдың әр мезгілінде кездеседі. Ат қорада ұстаған кезде жиі күзгі-қысқы мезгілде тіркеледі, табын кезінде жазғы жәе күзгі кезеңдерде кездеседі. Қолайсыз жағдайда (тығыз ұстағанда, толық азық бермеуден, ылғалдылығы, салқын тию, шаршататын айдау және т. б. ) барлық бас індетке сезімтал 2-3 ай аралығында. Өлім 30 . . . 70 пайызға дейін жетеді.
Спорадиялық жағдайда ауру эндогенді індет пайда болады. Ауру ауытқуы 3 . . . 5 пайыз. Өлім 1 . . . 7 пайызды құрайды.
Маңқаның қоздырушысы Pseudomonas mallei патматериалдан дайындаған жұғындыда шеттері жұмыр, жіңішке таяқша сияқты, ұзындығы 2-5 мкм, жуандығы 0. 5-0. 8 мкм. Жеке-жеке орналасады, кейде жұп түрінде . Микроб спора және капсула түзбейді.
Анилин бояуларымен бояуға болады, сілті қосса жақсы нәтиже береді. Мысалы: бояу мына құрамада: метилен көгінің қаныққан спиртті ерітіндісінің 3 бөлігінің, күйдіргіш натрийдің 0, 01% су ерітіндісінің 1 бөлігі. Дайын жұғынды 3 минут боялады. Осы әдіспен бояғанда маңқа таяқшаларының түйіршіктігі жақсы байқалады. Грам әдісімен боялмайды. Бөгде микроб жоқ, жарылмаған абсцесс, лимфа түйіндерінен және т. б. іріңді микроскопиялаудың балауда кейбір маңызы бар. Жарылған абсцессте және мұрын ағындысын микроскопиялау ештеңе бермейді.
Аурудың қоздырушысы 2-4% глицерин қосқан қарпайым қорекетік орталарда өседі, аэробты. Глицеринді ЕПА екінші тәулікте шырышты жабысқан ақ-сұр түсті болар-болмас қатпар пайда болады, бірте-бірте ол қоңырланады. Глицеринді ЕПС, тегіс бұлдырланады, қабырғаға жанас сақина және шырышты қабықша пайда, кейіннен ақ-сұр тұнба түседі. Инфекция қоздырғышының бастауы клиникалық ауру, ауырып жазылған және бактерия алып жүруші малдар жатады (бір жылдан асқан), қоздырғыш мұрын сөлінен, абцесс кезіндегі ірің, азықты ластайтын, төсеніші, суды. ТМД елдерінде маңқа жойылған, бірақта көрші Азия елдерінде бұл ауру әліде орын алады, демек оның біздің территориямызға ену қауіпі бар. Аурудың негізгі көзі ауру малдар, әсіресе ауру белгісі білінбейтін созылмалы түрімен ауыратындары. Негізінен жұқпалысы тыныс жолдарынан бөлінгендер, мұрындарынан аққандар және жұлынын қалған терідегі ойық жаралар. Осы бөлінгендер мал азығын, суатты, мал күтіміне қажет құрал-саймандарды сау малдарды залалдайды. Ауру негізінен ас қорыту аппараттары, сиректеу терісі арқылы жұғады. Тікелей жанасу арқылы да (түшкіру, пысқыру, осқыру, ойықшы жараны жалау) жұғуы ықтимал, бірақ ол сирек, демек ауру малды бірден жояды. Ал созылмалы ауыратындары байқаусыз қалып, ауру таратушылар болмақ.
1. 3 Маңқа ауруын жұқтыру жолы және патогенез
Сау малға алиментарлық және ауалы-тамшы, кейде контактті (иіскеу кезінде, пысқырғанда, емгенде) . Инфекция жолы болып мұрын жолының кілегей қабықтары және жұтқыншақ болып табылады. Бірнеше күнде 50 пайыздан астамы сезімтал келеди.
Вирустың берілу жолдары - қоршаған ортадағы заттар, контаминирленген қоздырғыш.
Қоздырғыш кілегейлі арқылы тысты желбезек лимфаның қырманымен лимфалық түйіншектерге өтіп кетед кейде жақасты. Стрептококк және оның токсиндері арқасында қабыну болады, басында серозды, сосын кілегейлі-іріңді мұрын кілегей қабығы отекпен және су, азық бергенде ауырсынумен өтеді. Жалпы жануардың жағдайы төмендейді, жүрек-қантамыр және тыныс алу жүйесі бұзылады. Жөтел мен ентігу пайда болады. Сөл ьтүйіндерінде іріңді фокус көрінеді, бір абцесске жиналып үлкейеді ді сыртқа шығады. Сол кезде дене температурасы қалыптасады, мұрыннан аққан соралар тоқтайды, іріңдеген жері дәнекер ұлпалармен толады және жазылады, оттек рассасываются. Жануар 2 . . . 3 аптадан соң жазылады. Осылайша індетті процесс маңқадың типиный формасы пайда болады.
Жас төлдерде резистенттілігі төмен кезінде маңқадың асқыну (метастатикалық) формасы. Қоздырғыш лимфогенді жолмен жұтқыншаққа кіреді, околоуышные, мойын лимфа түйіндерінде және олар іріңді қабынуды шақырады. Қоздырғыш қан арқылы кіруі мүмкін және өкпеде, бауырда, бүйректе және басқа мүшелерде жеңіл абцесс шақырады яғни септикопиемияны да шақыртады. Маңқадың асқынған формасы қызу көтерілумен, токсикозбен, жүрек қызметінің қабынуымен алып жүреді және өлімге әкеліп соқтырады.
1. 4 Маңқа аурының клиникалық белгілері
Маңқадыңі жасырын кезеңі ұзақтығы 1 . . . 15, орташа 4 . . . 8 күн. Күтпеген жағдайда маңқадың бірінші белгілері өзіне сай емес және ұзақтығы 1 . . . 2 апта, кейде ұзақ, ринит, фарингиттер, ларингиттер сияқты балайды. Бірақ күтпеген қоздырғыш құлындар сезімтал келеді, вируленттілігі жоғары және маңқадың клиникалық белгілері 4. . 5 күннен кейін көріне бастайды.
Ауру ұзақтығы жіті, кейде жітіден төмен. Маңқадың формалары өзіне тән, өзіне тән емес, түсікті, генитальді, метастатикалық болып ажыратылады.


Сурет 3. Маңқа ауруына шалдыққан жылқы және танаудан ағу белгілері
Маңқадың өзіне тән белгісі дене температурасының 40 . . . 410С күрт жоғарылауымен, тәбетінің төмендеуімен, арықтаумен, конъюнктиваның гиперемиясымен, мұрын қуысынан іріңді-катаральді бөлінумен, содан соң серозды-іріңді эксудатпен, ринитпен, фарингитпен, сырылданаған және қиындатылған демалумен, жөтелмен, жақ асты лимфа түйіндерінің ұлғаюямен және ауырсынумен, сондай ақ абсцедирленген (4-5 күнде) абсцестерді ашумен сипатталады. Азық және су қабылдауы қиындайды, жиі жылқыны саурғанда мұрыннан іріңді және кілегейлі сөл ағады. Қабынған оттек мойын аумағына таралады, жануар басын қозғалтпай ұстап алдыға созып тұрады. Абсцесті ашқан кезде дене температурасы нрмаға дейін төмендейді, кілегей қабықтң қабыну процессі қалыпқа келеді, ашылған абсцессс бірте -бірте некрозға айналады. Аурудың жалғасуы 15 . . . 25 күнге созылады.
Жіті формасы дене қызуының көтерілуінен басталады, азықтан бас тартады.
Танаудың кілегей қабықтарында сарғыш түйіндер шығады, олар некрозданады, оның орындарында ойықты жара пайда болады. Кілегейлі қабықтың қабынуына орай мұрыннан шырышты-ірің аға бастайды және алқым лимфа түйіндері іседі. Бірте-бірте мұрынның кіленейлі қабықтары жайылады және қосылып, көлемді ойықты жараға айналып білік тәрізді шеттерімен сау ұлпалардан бөлінеді. Ауру мал жөтеледі, пысқырады, ірің сыртқы ортаға шашылады, мал жүдейді. Шамамен 10-15% терінің үстіне, көбіне артқы аяқтарына алдымен түйін пайда болып, кейіннен жуан қабырғалы ойықты жара айналады. Маңындағы лимфа тамырлары ісініп жуандайды, жуан бауға ұқсайды. Осындай өзгерген лимфа тамырларының бойымен абсцесс түзіліп, кейіннен ойықты жараға айналады.
Созылмалы маңқаның клиникалық белгілеріне бірте-бірте арықтау, жөтел, мұрынынан іріңді сора, мұрынының жазылған кілегей қабықтарының орындарында жұлдыз тәріздес дәнекер ұлпалы тыртықтар пайда болады. Алқым сөл түйіндері үлкейген, нығыз, ауырмайды, терімен бітіскен. Аяқтарының терісінің үстінде абсцесс, ойықты жара, тыртық, лимфа тамырларының жуандауы кездеседі. Осыларға дәнекер ұлпаларының қарқынды өсуі ілеседі («піл аяқ») . Бірақта созылмалы аурудың жасырын өтіп, клиникалық белгілерінің байқалмауы мүмкін, ондай жағдайда аллергиялық және серологиялық әдістері көмекке келеді (малеинизация; КБР) . Маңқадың өзіне тән емес формасы абсцессіз өтеді жақ асты лимфа түйіндері және басқа клиникалық белгілері болады.
Маңқадың түсікті формасы еміп жүрген құлындар мен жылқылардың ересек сатысында жақсы ұстау және азықтандыру кезінде көрінеді. Бұл формадағы 52 пайызы маңқамен ауырғаны келеді. Мұрынның кілегей қабығы әлсіз байқалады, кілегейі іріңді ағумен қысқа мерзімде гипертермия, жақ асты лимфа түйінінің іріңдеу аздап ұлғаюымен байқалады. Бұл формасы зілсіз өтеді және 5 . . . 7 күннен кейін сауығады.

Сурет 3. Маңқа кезінде пайда болған жылқы мойнындағы ойық-жаралар
Биелердегі генитальді формасы шағылыстыру кезінде жұқтырылған, қынаптың кілегейлі қабықтың катаральді іріңді қабынумен келеді, перианальді және емшекті лимфа түйіндерінің абцессімен, кейде маститтермен, метриттермен және түсіктермен келеді. Айғырларда ауру жіті өтеді жыныс мүшесінің іріңді қабынуымен, орхиттермен және шап лимфа түйіндерінің қабынуымен, несеп бөлу жоладырының қабынуымен сипатталады.
Маңқадың метастатикалық (асқынған) формасы мұрынның кілегей қабығының іріңді қабынуымен, барлық лимфа түйіндерінің беті (жақасты, құлақ маңы, желке, тізе бүгілуінде) абцесстердің ақырын пісуі және маңы тығыздалумен, метастатикалық абцесстердің ішкі мүшелерде пайда болуымен сипатталады. Бұл абсцесстер ішін ашады, ірің жұтқыншаққа, трахеяға түсумен, аспирациялық бронхопневмониян мен плевропневмонияның пайда болуымен сипатталады. Бұл процесстер жоғары дене қызуымен, жүрек қызметінің әлсіздеуімен, өкпенің сықырлауымен, жануардың күрт өлуі мүмкін. Бауырдың метастатикалық абсцессі сар ауруға әкеп соқтырады. Жылқының лимфа түйіндерінде мезентальді абсцесс кезінде ішектерінде шаншу байқалады, асқазан ішек жолдарының бұзылуымен сипатталады. Абсцесстер буындарда, бас және арқа миында пайда болу мүмкін. Сол кезде, минингит, оглумоподобное жағдай артриттер апйда болады. Маңқадың әлсізденген жеке жылқылардың түпкі қызумен асқынатын ауру Morbus maculosis (қанды дақтармен болатын ауру) . Мұрын және конъюнктивалардың қанды дақтармен немесе нүктелі пайда болуымен, салқын, тығыз, бастың төменгі жағының ауырсынусыз болатын ісіктермен, содан аяқтың оттегімен, кеуде асты және қарын, қалақайлы бөртпелерге ұқсас болады. Дене температурасы 40 . . . 41 0 С көтеріледі, танау кең ісінген, қатты ентігу, тұншығу, терлеумен, әлсіздік, сары ауру пайда болады, мұрыннан қызыл қоңыр түсті сөл ағады демалатын ауа іріңді исіке айналады. Зілді түрде 3. . 4 күннен кейін өлімге ұшырайды, жағымды жақтарыда болады 8 . . . 14 күннен кейін сауғады және физиологиялық прцессстер біртіндеп қалыпқа келеді.
1. 5 Маңқа ауруынын өлген жануарда болатын патологоанатомиялық өзгерістер және балау
Маңқадан мерт болған жылқыны ашқан кезде көбінесе тыныс алу жүйесінің кілегей қабығында әне мұрын қуысында іріңді қабыну түрде өзіндік өзгерістер бар, сондай -ақ лимфа түйіндерінде іріңді лимфаденит түрде (жақасты, жұтқыншақ асты) ішкі лимфа түйіндерінде, ішкі мүшелерде кеуде және құрсақ қуыстарда - әр түрлі көлемде іріңді ошақтар, іріңді пневмония, плеврит, қанталаулар, сондай-ақ бауырда, бүйректе, миокарда дистрофиялық өзгерістер бар.
Балауды кешенді негізінде клинико-эпизоотологиялық деректер, патологоанатомиялық өзгерістерден, абцесстен щыққан іріңді, мұрыннан аққан, сондай-ақ мерт жануардан- ішкі мүшенің ақымданған участкілер және ашылмаған лимфа түйіндерің пат материалын бактериологиялық зерттеу жүргізеді. Соңғы балауды бөлінген және маңқалы стрептоккокт сәйкестендіру арқылы қояды.
Ажыратып балауды танау маңқадан (көзге маллеиндеуәдісімен және КБР қойылуымен), індеттік лимфангит, тұмау, ринопневмония, жұқпалы анемия, жұқпайтн этиоогиялық ринофарингитпен және т. б ажырату қажет.
1. 6 Маңқа ауруының емі және алдын алу шаралары
Ажырған және ауруға күдікті жылқыларды құрғақ және жылы бөлмее желсіз ықта оқшаулайды. Диеталық құнды және те қорытылатын азықпен кебектен (болтушек, көже) түрде қамтамасыз етеді. Ішетін суға 10 мл тұз қышқылын (НСІ) 10л суға қосады. Жергілікті ем қолданады суару түрде марганец қышқылды калий, фурацилин, риванол, Вишневский линиментімен, лизомен, 20%-ды АСД-2 ертіндісімен және т. б. Бастапқы ауруда абцесстердің тез пісуіне бас және мойынға жылытқыш компресстер тағайындайды, уақытында абцесстерді ашуын өткізеді. Антибиотиктер (пеницилинмен 25, 05 мың ӘБ/кг дозада), көк тамырға 33% этилды спиртті 30% сулы глюкоза ертіндіде қолданады. Маңқаға қарсы антивирусты (фильтрат 18 . . . 20 тәуліктік культуралар S. equi, ет-пептонды сорпада өсірілген) 50 . . . 100 мл дозада мойын аумағына және лимфалық түйіне бастапқы сатыда тері астына жібереді. Дәрілік заттарды енгізуді 2-4 күннен қайталайды. Асқынған жағдайда күпті ауруда ( петехиальной горячкой) 20%-ды кофеин ертіндісін, көк тамырға 10%-ды хлорлы кальций ертіндісін, 40%-ды уротропин ертіндісін, 150 . . . 250 мл камфорлы сарысу күнде қолданады.
Егер жұтқыншақ сөл түйіні шамадан тыс ісініп, тұншығу қаупі туса, трахеотомия жасайды.
Өзіне тән әдісіне КазНИВИ дәрі ұсынылған- этобиц (этоний+бициллин), бұлшық етке қолданады. Бұл дәрі дүниежүзілік жаңалық. Белсенді алдын -алу кезінде жылқыларды маңқаға қарсы инактивирленген вакцина «Стрептовак» (Қазақ НИВИ) қолданады. Вакцинаның дозасы 0, 1 мл килограмм дене массасына алдын-алу әсері 98%, шиеленіс иммунитеттің ұзақтығы 18 айға дейін, 0, 2 мл емдік әсері, толықтай жазылуы 6 . . . 7 тәулікте кепілдік береді.
Алдын-алу және күресу шаралар. Қатаң ветеринарлы -санитарлық шаралар орнатады, қоздырғыштың кіруіне ескеру, тәуелді жылқы басына алдын-ала карантиндеу, толлыққанды азықтандыру арқылы резистенттілігін жоғарлату, нормаланған микроклиматта ұстау және дұрыс пайдалану. Айғырларды послеотъемный кезеңде және жас жылқыларды желден қорғайды, салқын тиюден, салқын су көзден суаруды рұқсат етілмейді. Уақытылы ұстайтын жерде профилактиклық дезинфекция жасайды.
Маңқа шыға қалған жағдайда сау емеске шектеу қойылады, оқшаулап және ауру жануарды емдейді, уақытылы басқа жылқы басына ветеринарлық бақылау жүргізіледі, термометрия жүргізедібөлмеге, көсем және құрал-саймандарға дезинфекция жасайды. Сау емес немесе қауіп төнетін індеттік ошақтарға инактивирленген вакцинамен «Стрептовак» алдын-алу мақсатпен вакцина жасайды.
Биотермиялық қиды зарарсыздандырады 30 тәулік ішінде. Ауру толық жою кезінде қайта топтастыруды, жануарды әкелу және шығаруға тиым салынады. Жазылған жылқыларды жұмысқа біртіндеп жегеді.
Сау емес пунктен шектеуді 15 тәуліктен соң ең соңғы ауру малды және қорытынды шараларды өткізген соң алады.
2. Негізгі бөлім
2. 1 Патологиялық-анатомиялық өзгерістер және ашып сою хаттамасы
Анамнез: жылқының дене қызуы көтеріліп, тыныс алуы жиілеп, қатты күйзелу жағдайынжа болған. Терісінде жаралардың пайда болғанын байқаған.
Клиникалық белгілері: Дене температурасы 41-42 0- қа жоғарылаған, көзі мен танауының кілегей қабықтары қызарған, тамыр соғуы нашар, тыныс алуыда жиілеген, мал қатты күйзелген, танаудан қан аралас, сасық иісті жалқаяқ шығады. Малдың әлсін-әлсін ыстығы көтерілежі, өкпесі қабынады, әлсірейді. Мұрынның кілегей қабатында маңқалық ойық жаралыр пайда болған, малдың аяғында ісіне байқалады.
2. 2 Сыртқы қарау кезіндегі өзгерістер
Негізгі белгілері:
Өлік: жылқы тұқымы; етті бағыттағы
Жасы: 4, малдың түсі ; құла
Белгілері: 1, 50, 450 кг, тығыз, арықтаған.
Өліктегі өзгерістер: өлік сірескн, денесі салқынедаған, денеде түрлі ойық жаралары бар теріде ойық жаралар болады, бірақ тұяқ пен мүйізде өзгеріс болмайды, органдардың зақымданған.
Арнайы бөлім: қасаң қабықтар қызарады , саңылаулар байқалынады , теріде ойық жаралар болады, бірақ тұяқ пен мүйізде өзгеріс болмайды тері асты кличаткасы сөл тамырлары жуандайды бұлшық еттері мен сінірлерде өзгерістер болмайды , сүйекпен буында өзгеріс болмайды , лимфа түйіндері өзгерген, өлі еттенген ошақтар мен әк тұздарышөккен түйіншектер кездеседі , сүт бездері ісінген.
2. 3 Ішкі қарау кезіндегі өзгерістер
Құрсақ қуысы: өзгерістер болмайды, ағзаның орналасуы қалыпты деңгейде, сірліжапқыштарының жағдайы өзгермеген, диафрагма қалыпты деңгейде, іш майы қалыпты
Кеуде қуысы: өкпе қуысының өзгерісі. өкпеде шыны тәрізді жылтыр немесе ақшыл қоңыр маңқа түйнектері, олардың айналасында қызыл жиекшелер пайда болады.
Үлпершек жүрек тобы: калыпты
Плевза және жүрек жүрек қабының деңгейі: өкпеде өзгерістер болады, ал жүректе өзгерістер болмайды
Алдынғы шажырқайлы артерия: өзгермеген
Ауыз қуысының, майының және көкірек қуысының жағдайы: тісі, қызыл иек, таңдай қалыпты деңгейде, өзгерістер байқалмайды.
Сілекей бездері: жылтыр, әйнек тәрізді маңқа түйіндері сырт жағыфнда қызарған белдеумен қоршаулы боладыда, ортасында өметтенген ошақтар кездеседі.

Сурет 4. Маңқадан өлген жылқының өкпесі мен жүрек өуысындағы өзгерістер
Тіл. өзгерістер болмайды
жұтқыншақ және жұтқыншақ бездері қалыпты жағдайда, асқорыту. өзгерістер жоқ, қалқанша. қарбалас қалқанша бездері ісінеді, майының лимфа түйіндері ісінген, жүрек, тамырлар, қан зақамданбаған, көмекей және тахада өзгерістер білінбейді, бронхты және аралық перде лимфа түйіндері өлеттенген, ісінген, өкпеде шыны тәрізді жылтыр немесе ақшыл-қоңыр маңқа түйнектері байқалады.
Құрсақ және жамбас қуыстары: талақ, көкбауыр өзгерістер болада, негізгі індеттік белгілері кездеседі, өлі еттенеді, әктелген және қабықпен қапталған ұсақ түйіншектер пайда болады.
... жалғасы- Іс жүргізу
- Автоматтандыру, Техника
- Алғашқы әскери дайындық
- Астрономия
- Ауыл шаруашылығы
- Банк ісі
- Бизнесті бағалау
- Биология
- Бухгалтерлік іс
- Валеология
- Ветеринария
- География
- Геология, Геофизика, Геодезия
- Дін
- Ет, сүт, шарап өнімдері
- Жалпы тарих
- Жер кадастрі, Жылжымайтын мүлік
- Журналистика
- Информатика
- Кеден ісі
- Маркетинг
- Математика, Геометрия
- Медицина
- Мемлекеттік басқару
- Менеджмент
- Мұнай, Газ
- Мұрағат ісі
- Мәдениеттану
- ОБЖ (Основы безопасности жизнедеятельности)
- Педагогика
- Полиграфия
- Психология
- Салық
- Саясаттану
- Сақтандыру
- Сертификаттау, стандарттау
- Социология, Демография
- Спорт
- Статистика
- Тілтану, Филология
- Тарихи тұлғалар
- Тау-кен ісі
- Транспорт
- Туризм
- Физика
- Философия
- Халықаралық қатынастар
- Химия
- Экология, Қоршаған ортаны қорғау
- Экономика
- Экономикалық география
- Электротехника
- Қазақстан тарихы
- Қаржы
- Құрылыс
- Құқық, Криминалистика
- Әдебиет
- Өнер, музыка
- Өнеркәсіп, Өндіріс
Қазақ тілінде жазылған рефераттар, курстық жұмыстар, дипломдық жұмыстар бойынша біздің қор #1 болып табылады.



Ақпарат
Қосымша
Email: info@stud.kz